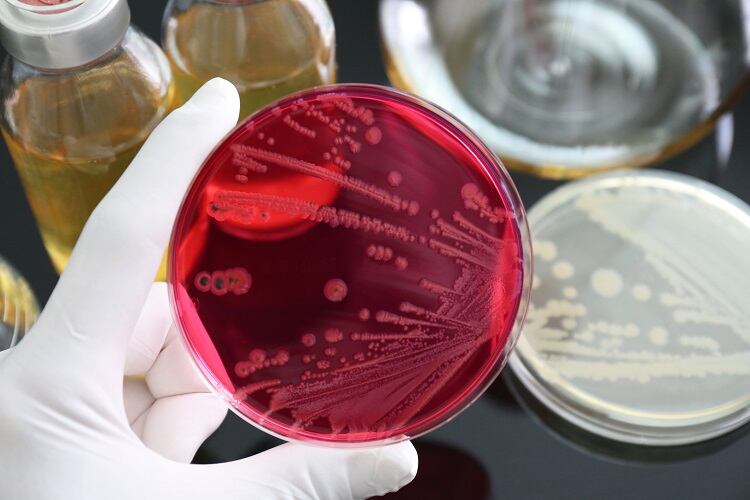

The European Commission has proposed a European Climate Law in an attempt to ensure climate neutrality by 2050. Elsewhere in the EU, Spain has banned retailers from selling food ‘at loss’, and UK regulators have tightened controls on raw milk production. FoodNavigator brings you news and views from across the bloc.

The European Commission has proposed a European Climate Law in an attempt to ensure climate neutrality by 2050. Elsewhere in the EU, Spain has banned retailers from selling food ‘at loss’, and UK regulators have tightened controls on raw milk production. FoodNavigator brings you news and views from across the bloc.

The European Commission has proposed a European Climate Law in an attempt to ensure climate neutrality by 2050.
The legally binding target of net zero greenhouse gas emissions would mean that EU institutions and Member States are ‘collectively bound’ to take the necessary measures at EU and national level to meet the target.
“The Climate law is the legal translation of our political commitment, and sets us irreversibly on the path to a more sustainable future,” said Commission President Ursula von der Leyen.
“It is the heart of the European Green Deal. It offers predictability and transparency for European industry and investors. And it gives direction to our green growth strategy and guarantees that the transition will be gradual and fair.”
The proposal includes measures to keep track of progress and adjust actions accordingly. It also addresses the pathway to get to the 2050 target:
- Based on a comprehensive impact assessment, the Commission will propose a new 2030 EU target for greenhouse gas emission reductions. The Climate Law will be amended once the impact assessment is completed.
- By June 2021, the Commission will review, and where necessary propose to revise, all relevant policy instruments to achieve the additional emission reductions for 2030.
- The Commission proposes the setting of a 2030-2050 EU-wide trajectory for greenhouse gas emission reductions, to measure progress and give predictability to public authorities, businesses and citizens.
- By September 2023, and every five years thereafter, the Commission will assess the consistency of EU and national measures with the climate-neutrality objective and the 2030-2050 trajectory.
- The Commission will be empowered to issue recommendations to Member States whose actions are inconsistent with the climate-neutrality objective, and Member States will be obliged to take due account of these recommendations or to explain their reasoning if they fail to do so. The Commission can also review the adequacy of the trajectory and the Union wide measures.
- Member States will also be required to develop and implement adaptation strategies to strengthen resilience and reduce vulnerability to the effects of climate change.
Image: GettyImages
According to the European Centre for Disease Prevention and Control (ECDC) and the European Food Safety Authority (EFSA), infections with foodborne bacteria are becoming harder to treat.
This is because a large proportion of Salmonella and Campylobacter bacteria are building up resistance against ciprofloxin – a popular antibiotic used to treat these illnesses.
Their research revealed that in 2018, sporadic cases of Salmonella infection was resistance to carbapenems – a ‘last-line’ antimicrobial.
“Finding carbapenem resistance in foodborne bacteria in the EU is a concern,” said ECDC’s chief scientist Mike Catchpole. “The most effective way to prevent the spread of carbapenem-resistant strains is to continue screening and respond promptly to positive detections.
“ECDC is working with EU Member States and with EFSA in a One Health approach to enhance the early detection and monitoring, in an effort to fight the persisting threat of antimicrobial-resistant zoonotic infections.”
EFSA’s and ECDC’s full report can be read here.
Image: Getty/Ca-ssis

The Food Standards Agency (FSA) has tightened the controls it expects to see in the production of raw drinking milk in England and Wales.
In collaboration with the Raw Milk Producers Association (RMPA) and other key stakeholders, the FSA has published the raw drinking milk guidance document.
According to the regulator, the document was developed in response to both a boost in raw drinking milk sales in recent years, as well as an increase in outbreaks of illness related to its consumption.
Unlike conventional dairy milk found on the supermarket shelf, raw drinking milk is not pasteurised – the process that kills off harmful bacteria. “Instead, it goes straight from the animal to the bottle,” explained the FSA.
“Raw drinking milk has a loyal following but is an inherently risky product because the way it’s produced increases the possibility of it containing harmful food poisoning bacteria,” said FSA’s Head of Food Safety Policy Michael Wight.
“It’s important to strike the right balance between protecting public health, preserving consumer choice and supporting responsible business. Food businesses must follow the measures set out in this guidance in order to reduce the health risk to consumers from this product.”
The guidance includes a number of safety measures raw milk producers must follow, including devising and implementing safety systems. The agency also expects producers to periodically test for specified pathogens and indicators of poor hygiene and disease in the milk.
Image: Getty/Diane Kuhl

Spain has brought in a new minimum food pricing law, which prohibits retailers from selling food for less than the cost of production.
According to the legislation, regulators will now be able to issue fines to retailers who partake in ‘sale at loss’. Fines will range from €3,000 to €100,000, however repeat offenders could me fined up to €1m.
The law falls under the Ley de la Cadena Alimentaria, or Food Chain Law, and governs business relationships between operators in the food chain.
Retailers will be exempt from sanctions if their ‘sale at loss’ concerns discounts of perishable products that are damaged, as well as promotions applied by distribution chains that assume the associated costs themselves.
While the agri-food sector has welcomed the law, describing it as a ‘historic conquest’, consumer organisations in Spain have expressed concerns the policy could result in higher food prices.
Image: Getty/zoff-photo

Three days ahead of International Women’s Day, the European Commission presented its strategy for equality between women and men in Europe.
While more women graduate from universities than men, they earn on average 16% less, and according to the Commission, just 8% of CEOs in the EU’s largest companies are women.
The Gender Equality Strategy 2025-2025 aims to stamp out injustices between gender across the bloc.
“Gender equality is a core principle of the European union, but it is not yet a reality. In business, politics and society as a whole, we can only reach our full potential if we use all of our talent and diversity,” said Commission President Ursula von der Leyen. “Using only half of the population, half of the ideas or half of the energy is not good enough.
“With the Gender Equality Strategy, we are pushing for more and faster progress to promote equality between men and women.”
According to the Commission, no EU Member State has achieved gender equality to date. The five-year strategy therefore outlines a set of key actions, including equal pay; and achieving gender-balance in decision-making and politics:
- In the EU 33% of women were subjected to physical and/or sexual violence, while 55% were sexually harassed. Women in Europe must be free from violence and harmful stereotypes. To achieve this, the Strategy calls for legal measures to criminalise violence against women. The Commission intends in particular to extend the areas of crime where harmonisation is possible across Europe to specific forms of violence against women, including sexual harassment, abuse of women and female genital mutilation. In addition, the Commission will propose the Digital Services Act to clarify what measures are expected from platforms to address illegal activities online, including online violence targeting women.
- Women in the EU earn on average 16% less than men and they still experience barriers to access and remain at the labour market. Gender equality is an essential condition for an innovative, competitive and thriving European economy. Given demographic challenges and green and digital transitions, supporting women to find jobs in sectors with skills shortages, in particular technology and AI sectors, will have a positive impact on Europe's economy. To address the unequal pay the Commission launches today a public consultation on pay transparency and will table binding measures by the end of 2020. To allow women to thrive in the labour market, the Commission will also redouble efforts to enforce EU standards on work-life balance to enable real choice for women and men to develop equally both personally and professionally. Gender equality in context of labour market, social inclusion and education dimensions, will continue to be monitored through the European Semester.
- Women remain underrepresented in leading positions, including EU's largest companies where only 8% of CEOs are women. To let women lead in business, among others, the Commission will push for the adoption of the 2012 proposal for gender balance on corporate boards. The Commission will also promote women's participation in politics, including in the 2024 European Parliament elections, including through funding and sharing best practice. To lead by example, the Commission will strive to reach gender balance of 50% at all levels of its management by the end of 2024.
Image: Getty/BulatSilvia

The Agriculture Bill is currently going through the UK Parliament. In the drafted version, the government is legally required to measure and report on ‘food security’.
This provision focuses on global food availability; where the food comes from; the resilience of the supply chain; data on household food expenditure, food safety and consumer confidence.
The provision does not focus on ‘household food security’, which has prompted MPs and not-for-profits to lobby for its inclusion in the Bill.
Labour MP for South Shields, Emma Lewell-Buck, has led a proposal seeking including of ‘household food security’ within the definition of ‘food security’ in Clause 17 of the Bill. Already, 16 other MPs have supported the amendment.
According to London think tank the Food Foundation, “adding three words to the Agriculture Bill will help parliament to monitor household food insecurity”.
For the not-for-profit’s chief executive Anna Taylor, the problem of food insecurity in the UK has been overlooked ‘for too long’.
“It leaves life-long scars on healthy and wellbeing. Now we have a chance to ensure parliament receives regular reports on the scale of the challenge so measures can be put in place to tackle it.
“This is a real opportunity to begin the end of the scourge on our society.”
Image: Getty/Ja'Crispy




